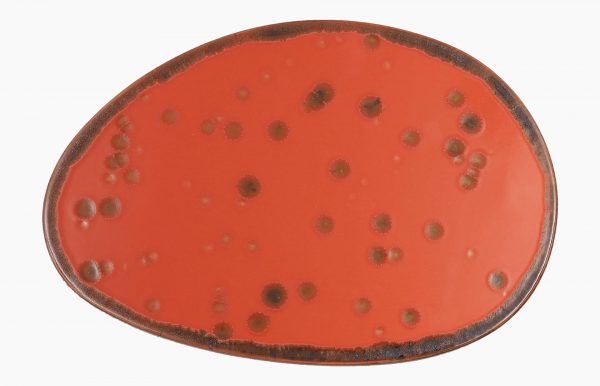

Sushi Tányér 27×18 cm
További információk
| Ápolás | |
|---|---|
| Szín | |
| Csomagolási egység | |
| Űrtartalom | |
| Átmérő |
Szakértelem a vendéglátásban
Többéves vendéglátói tapasztalatunkkal pontosan tudjuk, mire van szüksége a szakmában – segítünk a legjobb megoldásokat megtalálni.
Mindent egy helyen
Konyhafelszerelés, gépek és eszközök – nálunk mindent egy helyen beszerezhet, egyszerűen és kényelmesen.
Villámgyors szállítás
Nagy raktárkészletünknek köszönhetően a rendelések gyorsan célba érnek, hogy Önnek ne kelljen várnia.
Termékleírás
A 27×18 cm-es Mature sushi tányér a Moods koncepcióból. Teljesen lapos, és olyan darabok alapjául szolgál, mint a hosomaki hot roll, lehetővé téve a terrakotta szín, a sushi darabokban jelenlévő különböző színek és a porcelánra felvitt reaktív mázak közötti erős kontrasztot.